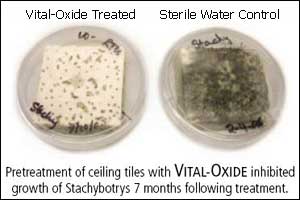
Ceiling Tiles treated with Vital-Oxide

Vital Oxide Disinfectant Gallon Refill Bottle
This product provides relief from: Bacteria & Germs, Mold & Mildew
Vital Oxide® is a broad-spectrum, antimicrobial solution proven to perform against molds, mildews, fungi, spores, yeasts, and viruses. Use Vital Oxide in shower stalls, under sinks, on kitchen counters, in diaper pails, at schools, in daycares, on sports equipment, in basements – anywhere mold or bacteria can be found. Vital Oxide Antibacterial Spray has been independently tested under GLP (good laboratory practice) conditions and shown to kill bacteria and viruses, such as MRSA, H1N1 (Swine Flu), Norovirus, Legionella pneumophila, and E. coli. No job is too big or too small for Vital Oxide!
Vital Oxide comes in a one-gallon (128-oz) refill size that is affordably priced, and great for big jobs. Also available in a ready-to-use 32-oz spray bottle, and a handy 3-oz travel size with pump sprayer (both sold separately).
Why Vital Oxide?
- Vital Oxide comes from the family of revolutionary products brought to you by The Ecology Works®, whose products strike at the root causes of many common allergic reactions
- Vital Oxide is a hospital-grade disinfectant that kills 99.999% of harmful microbial substances on hard surfaces and in the air
- Kills Bacteria and Virus and for use against Ebola virus
- Awarded the Carpet and Rug Institute (CRI) Seal of Approval, Vital Oxide is also effective at sanitizing carpets and removing pet odors
- Though tough on molds, mildew, fungi, yeasts, bacteria and viruses, Vital Oxide is gentle on you
- Vital Oxide is for someone who wants an antimicrobial cleaner that's:
- An ecologically sound alternative to chlorine-based cleaners and disinfectants
- Safe for you, your family, and for environment
- So mild you can wash your hands in it
- Note: Moms find it great to clean and sanitize toys safely and easily – especially bathtub toys!
- Non irritating to the skin, and non corrosive to treated articles
- Colorless, odorless, and will not harm water-safe fabrics
- Gallon size perfect for big jobs or to have extra on hand
- EPA registered
Ingredients:
Chlorine Dioxide, n-Alkyl Dimethyl Benzyl Ammonium Chloride, n-Alkyl Dimethyl Ethylbenzyl Ammonium Chloride, Inert Ingredients.
MSDS:
Click here to see the MSDS for Vital Oxide.
Active Ingredient:
The active ingredient in Vital Oxide is chlorine dioxide, which sounds like chlorine, but it's not. Chlorine dioxide and chlorine are very different, react differently, and result in different by-products (see chart below). Chlorine dioxide has been used in disinfecting water supplies for decades, but only now, in Vital Oxide, is there a formula that is stable enough to remain potent for home use.

| Results of Independent Study on Vital Oxide... |
|
![]() |
An independent study by the University of Tulsa showed that Vital Oxide was effective in controlling fungal contamination on building materials. Sheetrock treated with Vital-Oxide exhibited no fungal growth as compared to significant mold growth on the untreated control sample. In another test, one ceiling tile was treated with Vital Oxide, while only sterile water was applied to the other. Then both were exposed to toxic black mold (stachybotrys). As the image shows, the results were impressive... even after 7 months! |
Directions for Use: - Always refer to the product label for full instructions.
| Note: | Vital Oxide is safe for your family and the environment and has absolutely no chlorine smell. Vital Oxide is odorless, however, if you have previously used a chlorine-based product on the surface you are treating, Vital Oxide could react with any residue causing you to notice the smell of chlorine. |
- To Clean and Disinfect Hard Non-Porous Surfaces:
- Pre-clean surface with warm soapy water, rinse and allow to dry.
- Apply Vital Oxide full strength, enough to thoroughly wet surface.
- Allow surface to remain wet for 5 minutes for viral inactivation – 10 minutes for bacterial disinfection.
- For immersion applications, replace solution daily, or more frequently if it becomes significantly soiled or diluted.
- No rinsing required, just air dry.
- To Clean and Disinfect Floors:
- Sweep or vacuum floor to remove particles.
- Mop the floor with warm, soapy water to remove any dirt or stains, rinsing the mop with clean water frequently.
- Apply Vital Oxide at a dilution of 5 parts water to 1 part Vital Oxide.
- No rinsing required, just air dry.
- Do NOT use Vital Oxide on non-sealed wood floors.
- To Pre-Treat and Sanitize Synthetic Carpets:
- Vital Oxide can be used to treat synthetic carpet fibers, like nylon, olefin or polypropylene. Do NOT use Vital Oxide on wool carpets.
- First, prepare carpet by cleaning or vacuuming up excessive dirt.
- If carpet holds any chemicals from previously used products, be sure to clean carpet before applying Vital Oxide.
- To Pre-treat carpet stains – apply Vital Oxide at a dilution of 10oz to 1gal (128oz) to cover 200 sq. ft.
- To Sanitize carpets:
- First, test for color fastness in an inconspicuous area.
- Vacuum up any loose dirt and debris.
- Apply Vital Oxide that's been diluted 5 parts water to 1 part Vital Oxide at a rate of 1.7 gallons per 10 sq. yards (or approx. 22oz per sq. yd.). Because Vital Oxide must come in contact with contaminants in order to work, be sure to apply over the entire carpet area to be treated.
- Allow Vital Oxide to remain on carpet for 10 minutes.
- Do not rinse. Remove any excessive moisture by either blotting or wiping with a dry towel or use a water extraction wand.
- Allow carpet to air dry or use blowers or fans if quicker drying is required.
Note: Vital Oxide can also be used in a fogger for big jobs.